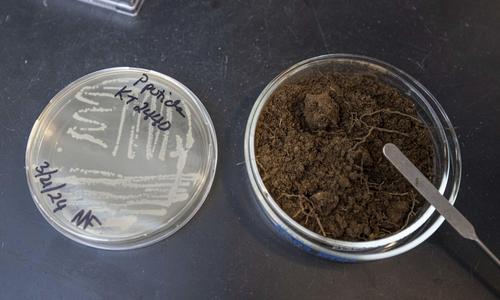

Worcester Polytechnic Institute (WPI) researcher Natalie Farny is launching a $1.2 million, five-year project that could advance the use of bacteria for environmental cleanups by determining how a critical biological process regulates genes in bacteria as they adapt to conditions outside of laboratories.
Farny, an assistant professor in the Department of Biology and Biotechnology, will examine the role of methylation on gene expression in Pseudomonas putida, a soil bacteria that was first identified in Japan and is considered a versatile organism for industrial and environmental engineering. The National Science Foundation has awarded Farny a prestigious CAREER Award to fund the project, which will provide research opportunities for WPI students and generate new undergraduate educational resources focused on synthetic biology, a field that applies engineering design principles to build novel biological systems for use in fields such as medicine, manufacturing, and agriculture.
Samples from Farny's lab show, at left, bacteria, and at right, soil.
“Genetically engineered bacteria have the potential to break down contaminants in soil, whether they are explosive materials deposited on military firing ranges or chemicals left behind by industry,” Farny said. “To engineer stable bacteria that behave in predictable and desirable ways once they are released into the environment, however, it will be essential to better understand how their genes are impacted by the environment.”
Farny’s project focuses on methylation, a biological process that can be triggered by environmental factors. Methylation adds a chemical, known as a methyl group, to an organism’s genome. This addition can influence how the organism’s genes are expressed. In bacteria, which are single-cell organisms abundant in nature, methylation is a key factor in regulating gene expression.
Farny will investigate the impact of methylation on gene expression of P. putida in soil and in a laboratory system that uses a liquid containing organic matter extracted from soil. She also will build gene circuits, which are networks of genes and regulatory elements that interact with each other, to test engineered P. putida under soil-like conditions.
As part of her project, Farny will create free educational resources to introduce undergraduate students to synthetic biology, develop material for her synthetic biology course, and integrate synthetic biology into research projects for undergraduates in her lab. Project funds also will support at least two graduate students a year in their work, as well as summer research opportunities for two to three undergraduates a year.
The project builds on Farny’s previous research into cell stress responses, biological sensors that could assist in remediating environmental contaminants, and methods for studying bacteria. The fundamental knowledge gained from insights into cells and their environment could lead to advances in cleaning up soil to grow food for Earth’s growing population, which makes the research important and compelling, Farny said.
“The interaction between a cell and its environment has always fascinated me,” Farny said. “This project explores an interaction that has the potential to impact a matter critical to humanity. If we want to feed a growing population, if we want clean drinking water from ground sources, we will need to nurture and reclaim compromised soil. Engineered bacteria are good candidates for this work.”